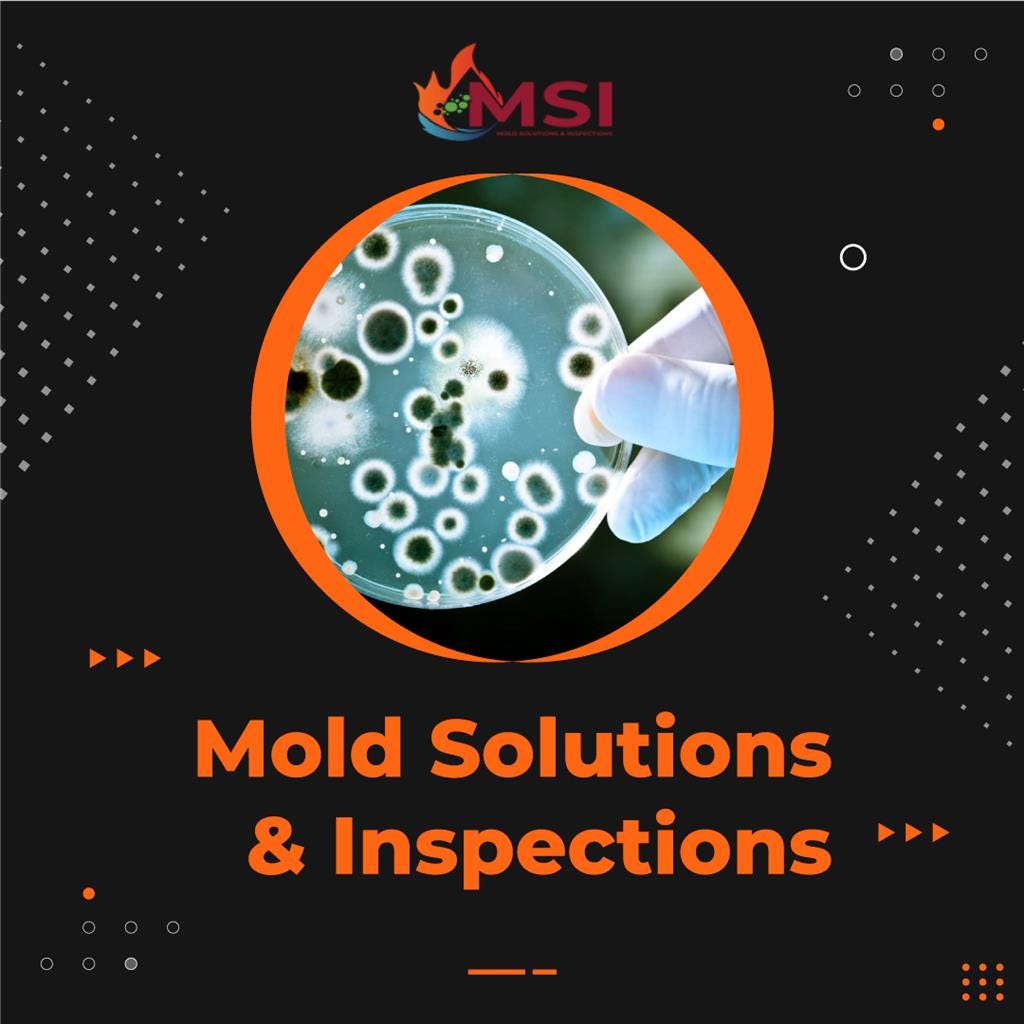
Mold Inspection Services Mold Solutions &

Moose Jaw 4A Property Inspection Services – full inspections – pre-listing inspections – move-in certified – ozonation – mold and electrical inpections. 18 years of combined experience inspecting commercial and real estate & 50 years of combined experience in the building industry.. Message. Mold Removal or Remediation needed in Moose Jaw: Special Requirements or Questions. If you needing immediate assistance please call toll free. 1- 866 300 55570 / 180. Send Message. Find answers to all your pressing mold-related questions. Moose Jaw’s leading experts in mold restoration clear the air for you.

Moose Jaw benefitting from worldwide attention 650 CKOM

‘Days are long’ Moose Jawarea farm family in midst of harvest 650 CKOM

Foundation Inspection Moose Jaw 4A Property Inspection

Mold Inspection Up Country Building Inspectors

Moose Jaw Map Saskatchewan, Canada Detailed Maps of Moose Jaw
Mold Inspection Services Mold Solutions & Inspections Medium

Trusted Mold Removal and Inspection Services in UAE Hitches & Glitches

A typical mold inspection involves the inspector talking to the property owner about any areas

Moose jaw saskatchewan hires stock photography and images Alamy
-1920w.png)
Mold Testing In Clearwater, FL The Mold Girl of Clearwater

Calaméo Mold Inspection Hialeah FL

Moose Track Mold Adult Front

Moose Track Mold Adult Front

Mold Inspection Services in Kansas City

29 HQ Photos Free Firewood Moose Jaw 009 Saskatchewan Moose Jaw Moose Jaw River Park

Trenton, NJ Call STOP Restoration of Edison For Mold Inspection Services

How to Pick Your Wedding Venue in the Moose Jaw + Regina area

Lisa’s Corner Moose Jaw TimesHerald Healthy Weights Initiative surpasses goal

Paice Construction General Contractors Moose Jaw & Area Saskatchewan

Mold Inspection Services Mold Solutions & Inspections Medium
Blake Pitts, CMI – Moose Jaw, SK Certified Home Inspector – InterNACHI®. backed by InterNACHI. Call Blake at. (306) 690-3333.. Mark Paterson – Moose Jaw, SK Certified Home Inspector – InterNACHI®. $25,000 Honor Guarantee backed by InterNACHI. Call Mark at. (306) 631-6700.




